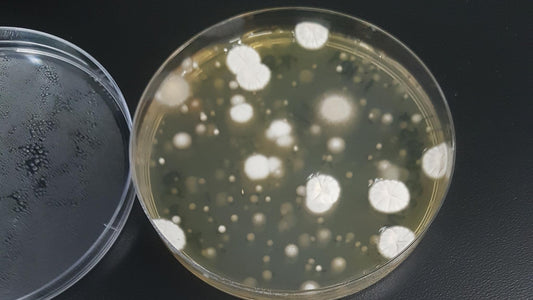

Hurtigt svar og nem at indsende prøve
den virkede tilsyneladende som den skulle
Modtog 2 stk runde plast forme hvor den ene var defekt og med tydelig svampe sporer inden i da jeg tog den ud af pappet, den lugtede af våd kælder. Mega træk da jeg havde købt 2 stk så jeg kunne tjekke hjemme samt på mit job.De lange rør mangler at man kan scanne og se en video om hvordan den skal bruges
Hej Sussi
Dejligt at vi fik løst problemet med din ordre nemt og hurtigt! Vi håber du er blevet glad for dine tests, og ellers står vores team klar til at hjælpe dig!
De virkede som de skulle, altså petriskålene